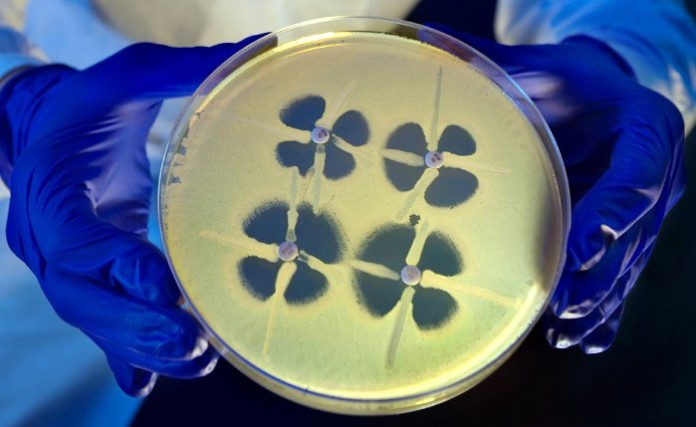

Unas bacterias resistentes a los antibióticos relativamente nuevas, las Enterobacterias Resistentes a los Carbapenemes, están avanzando en algunas ciudades estadounidenses importantes, según informan las autoridades sanitarias de EEUU.
Los servicios de vigilancia de siete áreas metropolitanas de EE. UU. hallaron unos niveles más altos de los anticipados de las ERC en Atlanta, Baltimore y la ciudad de Nueva York, según los Centros para el Control y la Prevención de Enfermedades (CDC) de EEUU.
Se encontraron niveles más bajos de lo esperado en Albuquerque, Denver y Portland (Oregón), y la tasa de Minneapolis fue la prevista por la agencia.
Pero los investigadores de los CDC se sintieron consternados al encontrar casos activos de infecciones con las ERC en todas las ciudades que examinaron, comentó el autor principal, el Dr. Alexander Kallen, funcionario médico de los CDC.
Los resultados respaldan la decisión de los CDC de fomentar la realización de esfuerzos coordinados para la prevención de la propagación de las ERC y otras bacterias resistentes a los antibióticos, dijo Kallen.
“Aquí tenemos la oportunidad de intervenir en uno de los organismos resistentes a múltiples medicamentos justo ahora que está a punto de extenderse y que todavía es relativamente poco frecuente”, dijo. “Es el momento en que se debe intervenir. Es mucho más sencillo controlar las cosas y evitar que el organismo se vuelva más habitual cuando su presencia es poco frecuente”.
Aproximadamente el 9 por ciento de las personas fallecieron a causa de su infección con las ERC, según los investigadores. Pero algunas estimaciones han propuesto que hasta el 50 por ciento de los casos de infección con las ERC contribuyen al fallecimiento si llevan a una infección del torrente sanguíneo, comentó Kallen.
Las ERC (Enterobacteriaceae resistentes a los carbapenemes) son una clase de bacteria común que han desarrollado una resistencia a algunos de los antibióticos que se usan más habitualmente, explicó Kallen. El primer informe sobre las ERC apareció en 2001.
Las enterobacterias más conocidas son la Escherichia coli, una causa común de Klebsiella pneumoniae, que puede provocar neumonía y potencialmente infecciones fatales del torrente sanguíneo, dijo Kallen.
Las bacterias ERC son capaces de producir una enzima que descomponen a los antibióticos, lo que fuerza a los médicos a recurrir a antibióticos más antiguos y más tóxicos para combatir las infecciones, dijo.
La mayoría de las infecciones con las ERC se producen en un hospital. De hecho, la hospitalización fue la exposición potencial más habitual de las ERC, halló el estudio. La edad media (el valor medio) de los pacientes fue de 66 años.
Pero a los expertos en la salud pública les preocupa que, dado que las enterobacterias son tan habituales en la vida cotidiana, si las ERC empiezan a transmitirse fuera de los ámbitos de la atención sanitaria podrían causar estragos.
“Estamos viendo a cada vez más pacientes en la comunidad con una infección renal por E. coli ante la cual no contamos con una terapia oral para su tratamiento”, dijo la Dra. Mary Hayden, profesora asociada de patología del Centro Médico de la Universidad de Rush en Chicago. “Si las ERC entran en la comunidad y empiezan a provocar infecciones comunes y corrientes en el tracto urinario en personas que por lo demás están sanas, tendrían un impacto significativo porque no tenemos agentes para tratar esas cosas”.
En el estudio, publicado el 5 octubre en la revista Journal of the American Medical Association, los CDC realizaron una vigilancia activa de las ERC en 2012 y 2013 en las personas que viven en las siete ciudades mencionadas anteriormente.
La tasa general de ERC en esas ciudades fue de 2.93 infecciones por cada 100,000 personas, hallaron los investigadores.
Es una cifra baja en comparación con el SARM, una bacteria resistente a los antibióticos, y la bacteria oportunista Clostridium difficile, que provoca una diarrea potencialmente letal en personas con un sistema digestivo al que se han administrado antibióticos fuertes.
Pero las ERC se han vuelto más habituales en un periodo corto de tiempo, dijo Hayden, que escribió un editorial acompañante en el revista.
“Creo que hemos aprendido a partir de esas situaciones que estos problemas se pueden propagar con mucha rapidez”, dijo. “Si observamos lo que ha ocurrido con otros organismos resistentes a los antibióticos parecidos, podemos ver lo que ocurrirá con este a menos que hagamos algo ahora”.
Para detener la propagación de las bacterias resistentes a los antibióticos, los CDC están promoviendo que se realicen esfuerzos regionales en los que los hospitales, los centros de atención médica a largo plazo y otros centros de atención médica se comuniquen regularmente sobre las infecciones, dijo Kallen.
Muchas bacterias resistentes a los antibióticos se propagan en una comunidad porque las portan los pacientes de un centro a otro. Una mejor coordinación puede prevenir esta propagación al identificar a los pacientes y aislarlos con un buen control de las infecciones, comentó.
Hayden elogió este estudio como un “paso inicial realmente bueno”, pero dijo que espera que se expanda hasta incluir a muchas otras áreas metropolitanas.
“Esto da una buena idea del panorama a nivel nacional, pero se puede mejorar”, dijo.
Fuente: IntraMed